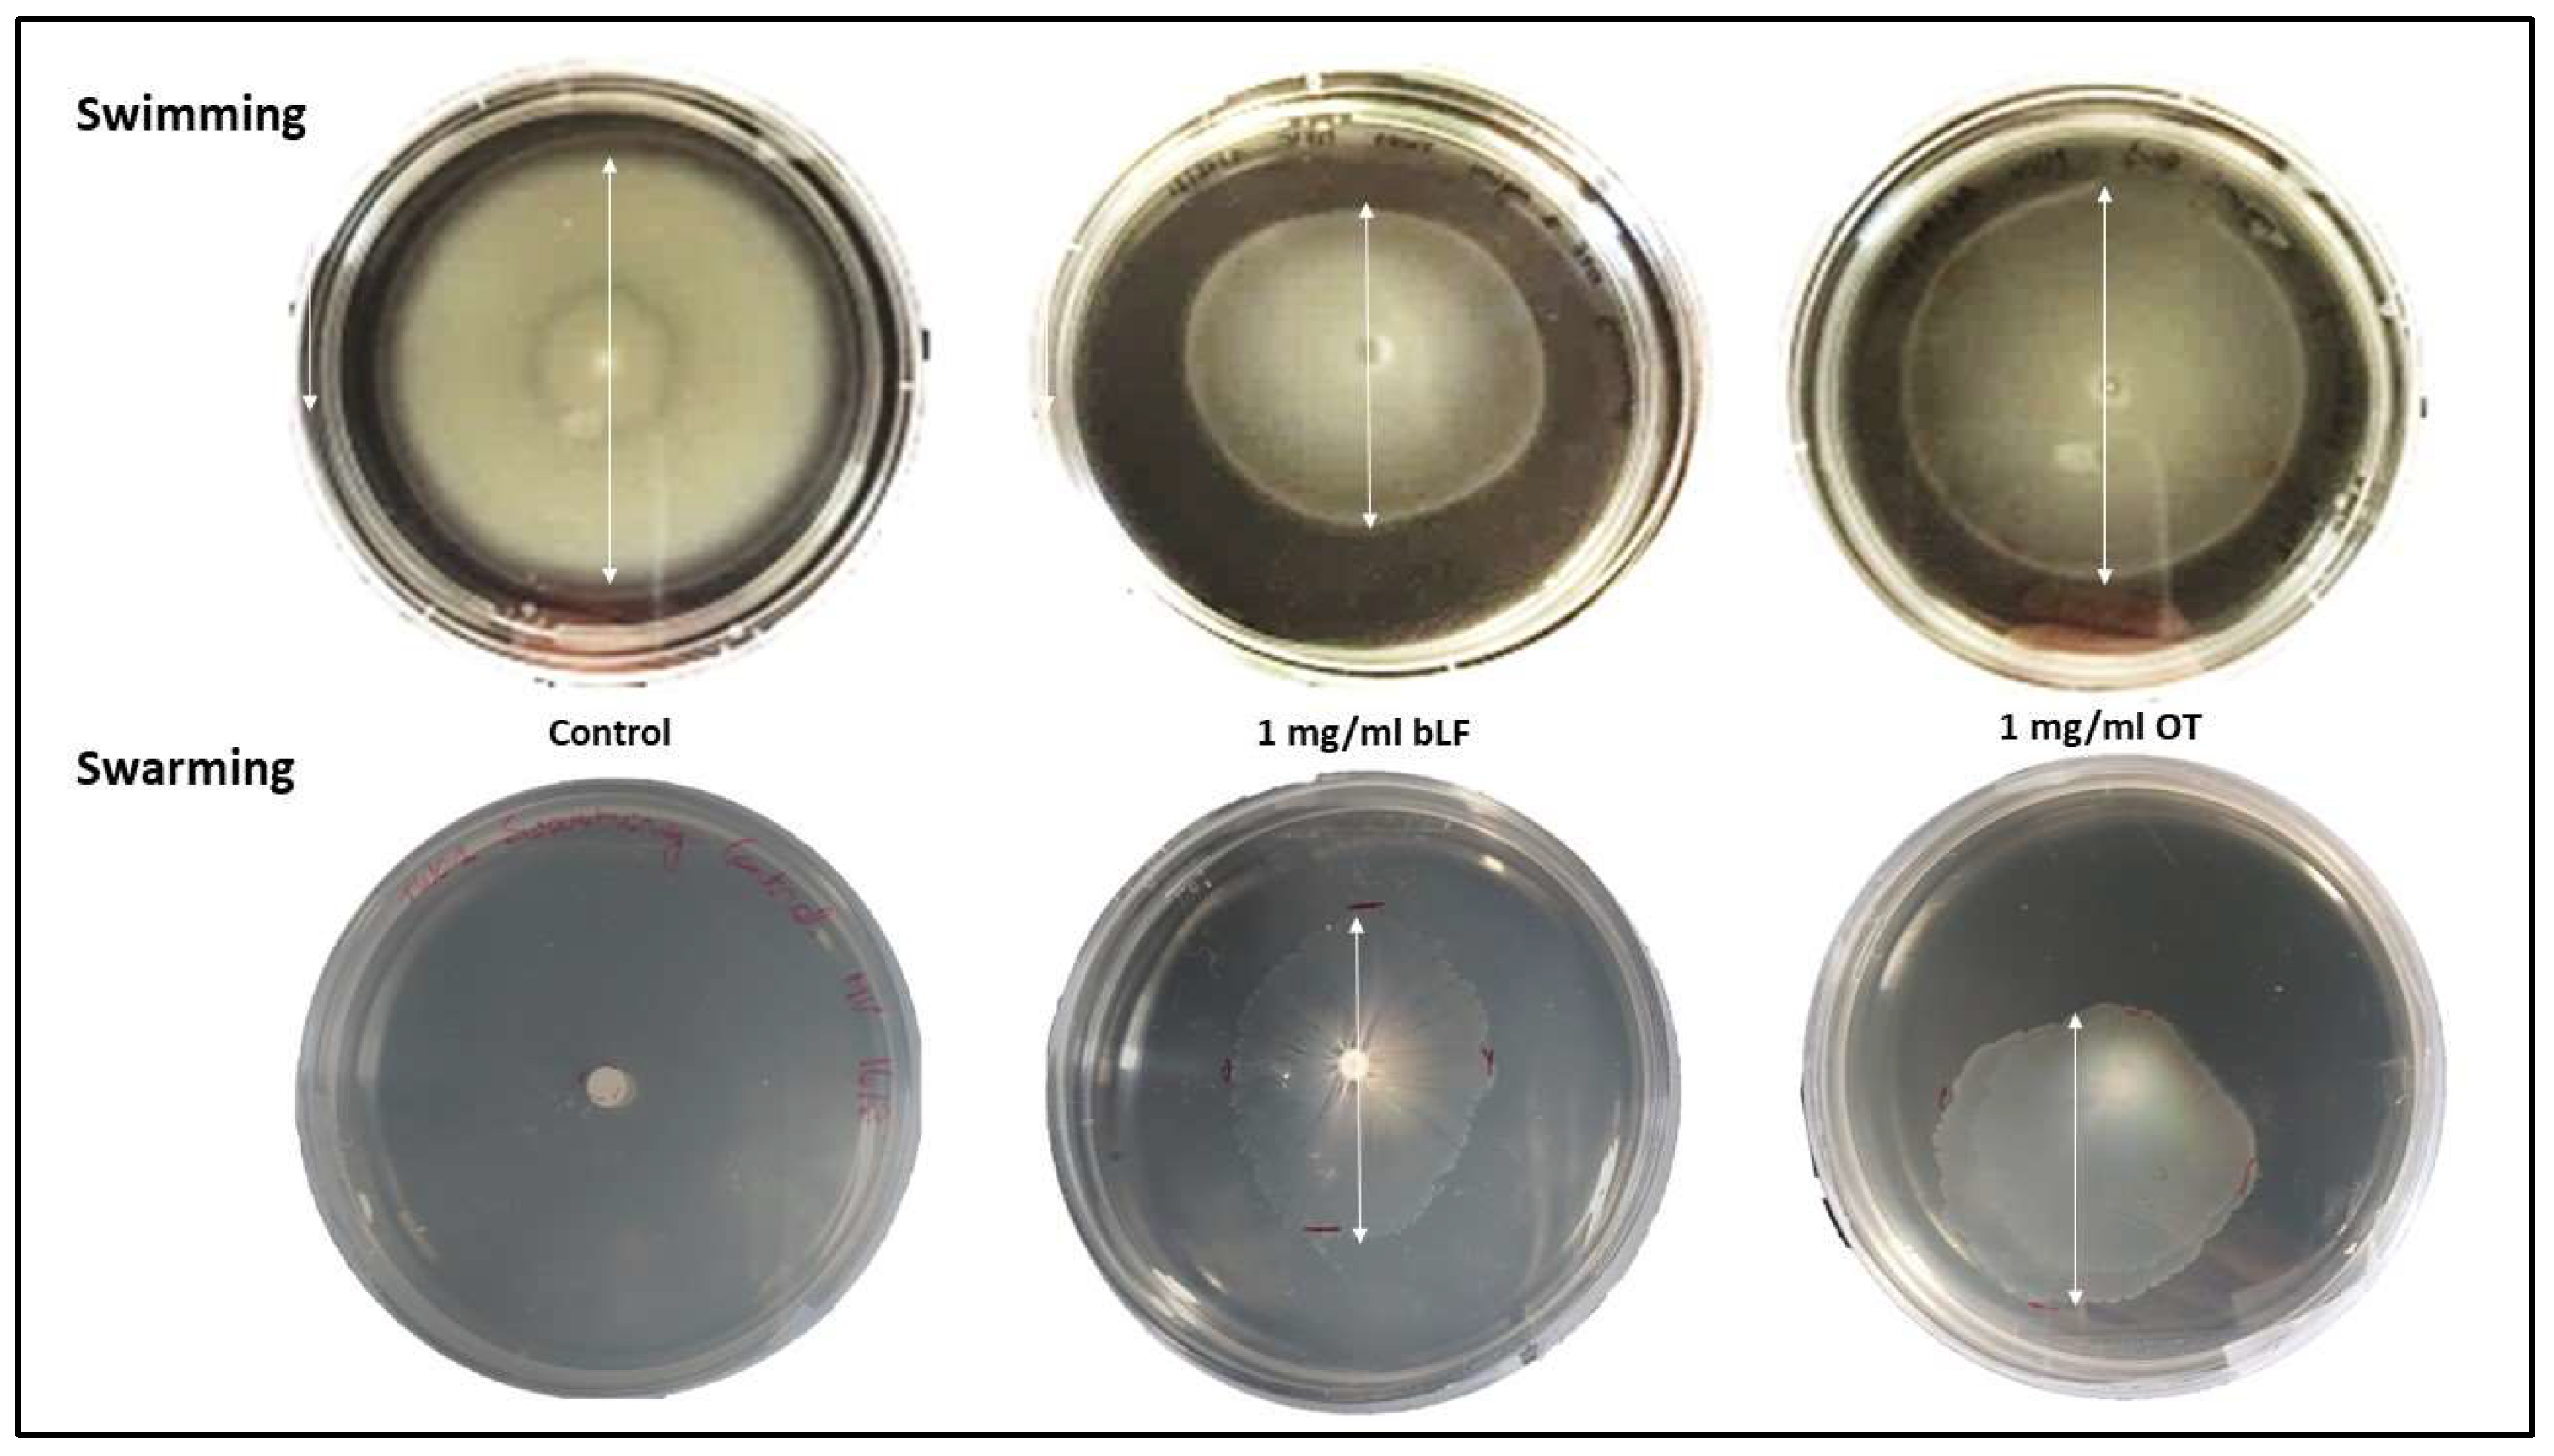
Microorganisms 11 02912 g007

Bovine Lactoferrin and Hen Ovotransferrin Affect Virulence Factors of Acute Hepatopancreatic Necrosis Disease (AHPND)-Inducing Vibrio parahaemolyticus Strains
Abstract
:1. Introduction
2. Materials and Methods
2.1. Transferrins
2.2. Bacterial Strains and Growth Conditions
2.3. PirAB Production by Vp Test Strains
2.4. Effect of bLF and OT on Bacterial Growth
2.5. Effect of bLF and OT on Bacterial Virulence Factors
2.5.1. Biofilm Formation
2.5.2. Swimming and Swarming Motility
2.5.3. Cell Surface Hydrophobicity (CSH)
2.5.4. Extracellular Enzyme Activity
2.5.5. Statistical Analysis
3. Results
3.1. PirAB Production by Vp Test Strains
3.2. Effect of bLF and OT on Bacterial Growth
3.3. Effect of bLF and OT on Bacterial Virulence Factors
3.3.1. Biofilm Formation
3.3.2. Swimming and Swarming Motility
3.3.3. Cell Surface Hydrophobicity (CSH)
3.3.4. Extracellular Enzyme Activity
4. Discussion
5. Conclusions
Supplementary Materials
Author Contributions
Funding
Data Availability Statement
Acknowledgments
Conflicts of Interest
References
- Kumar, R.; Ng, T.H.; Wang, H.C. Acute hepatopancreatic necrosis disease in penaeid shrimp. Rev. Aquac. 2020, 12, 1867–1880. [Google Scholar] [CrossRef]
- Kumar, V.; Roy, S.; Behera, B.K.; Bossier, P.; Das, B.K. Acute hepatopancreatic necrosis disease (Ahpnd): Virulence, pathogenesis and mitigation strategies in Shrimp aquaculture. Toxins 2021, 13, 524. [Google Scholar] [CrossRef] [PubMed]
- Soto-Rodriguez, S.A.; Lozano-Olvera, R.; Montfort, G.R.C.; Zenteno, E.; Sánchez-Salgado, J.L.; Vibanco-Pérez, N.; Aguilar Rendón, K.G. New Insights into the Mechanism of Action of PirAB from Vibrio Parahaemolyticus. Toxins 2022, 14, 243. [Google Scholar] [CrossRef] [PubMed]
- Han, J.E.; Tang, K.F.J.; Tran, L.H.; Lightner, D.V. Photorhabdus insect-related (Pir) toxin-like genes in a plasmid of Vibrio parahaemolyticus, the causative agent of acute hepatopancreatic necrosis disease (AHPND) of shrimp. Dis. Aquat. Org. 2015, 113, 33–40. [Google Scholar] [CrossRef]
- Lee, C.T.; Chen, I.T.; Yang, Y.T.; Ko, T.P.; Huang, Y.T.; Huang, J.Y.; Huang, M.F.; Lin, S.J.; Chen, C.Y.; Lin, S.S.; et al. The opportunistic marine pathogen Vibrio parahaemolyticus becomes virulent by acquiring a plasmid that expresses a deadly toxin. Proc. Natl. Acad. Sci. USA 2015, 112, 10798–10803. [Google Scholar] [CrossRef]
- Muthukrishnan, S.; Defoirdt, T.; Ina-Salwany, M.Y.; Yusoff, F.M.; Shariff, M.; Ismail, S.I.; Natrah, I. Vibrio parahaemolyticus and Vibrio harveyi causing Acute Hepatopancreatic Necrosis Disease (AHPND) in Penaeus vannamei (Boone, 1931) isolated from Malaysian shrimp ponds. Aquaculture 2019, 511, 734227. [Google Scholar] [CrossRef]
- Dong, X.; Bi, D.; Wang, H.; Zou, P.; Xie, G.; Wan, X.; Yang, Q.; Zhu, Y.; Chen, M.; Guo, C.; et al. pirABvp-Bearing Vibrio parahaemolyticus and Vibrio campbellii pathogens isolated from the Same AHPND-affected pond possess highly similar pathogenic plasmids. Front. Microbiol. 2017, 8, 1859. [Google Scholar] [CrossRef] [PubMed]
- Ke, H.M.; Prachumwat, A.; Yu, C.P.; Yang, Y.T.; Promsri, S.; Liu, K.F.; Lo, C.F.; Lu, M.Y.J.; Lai, M.C.; Tsai, I.J.; et al. Comparative genomics of Vibrio campbellii strains and core species of the Vibrio Harveyi clade. Sci. Rep. 2017, 7, srep41394. [Google Scholar] [CrossRef]
- Kondo, H.; Van, P.T.; Dang, L.T.; Hirono, I. Draft genome sequence of non-Vibrio parahaemolyticus acute hepatopancreatic necrosis disease strain KC13.17.5, isolated from diseased shrimp in Vietnam. Genome Announc. 2015, 3, e00978-15. [Google Scholar] [CrossRef]
- Liu, L.; Xiao, J.; Zhang, M.; Zhu, W.; Xia, X.; Dai, X.; Pan, Y.; Yan, S.; Wang, Y. A Vibrio owensii strain as the causative agent of AHPND in cultured shrimp, Litopenaeus vannamei. J. Invertebr. Pathol. 2018, 153, 156–164. [Google Scholar] [CrossRef]
- Restrepo, L.; Bayot, B.; Arciniegas, S.; Bajaña, L.; Betancourt, I.; Panchana, F.; Reyes Muñoz, A. PirVP genes causing AHPND identified in a new Vibrio species (Vibrio punensis) within the commensal Orientalis clade. Sci. Rep. 2018, 8, 13080. [Google Scholar] [CrossRef] [PubMed]
- Sathiyamoorthi, E.; Faleye, O.S.; Lee, J.H.; Raj, V.; Lee, J. Antibacterial and Antibiofilm Activities of Chloroindoles Against Vibrio parahaemolyticus. Front. Microbiol. 2021, 12, 714371. [Google Scholar] [CrossRef] [PubMed]
- Lulijwa, R.; Rupia, E.J.; Alfaro, A.C. Antibiotic use in aquaculture, policies and regulation, health and environmental risks: A review of the top 15 major producers. Rev. Aquac. 2019, 12, 640–663. [Google Scholar] [CrossRef]
- Elmahdi, S.; DaSilva, L.V.; Parveen, S. Antibiotic resistance of Vibrio parahaemolyticus and Vibrio vulnificus in various countries: A review. Food Microbiol. 2016, 57, 128–134. [Google Scholar] [CrossRef] [PubMed]
- Tan, C.W.; Rukayadi, Y.; Hasan, H.; Thung, T.Y.; Lee, E.; Rollon, W.D.; Hara, H.; Kayali, A.Y.; Nishibuchi, M.; Radu, S. Prevalence and antibiotic resistance patterns of Vibrio parahaemolyticus isolated from different types of seafood in Selangor, Malaysia. Saudi J. Biol. Sci. 2020, 27, 1602–1608. [Google Scholar] [CrossRef] [PubMed]
- Stratev, D.; Fasulkova, R.; Krumova-Valcheva, G. Incidence, virulence genes and antimicrobial resistance of Vibrio parahaemolyticus isolated from seafood. Microb. Pathog. 2023, 177, 106050. [Google Scholar] [CrossRef] [PubMed]
- Abdelnour, S.A.; Ghazanfar, S.; Abdel-Hamid, M.; Abdel-Latif, H.M.R.; Zhang, Z.; Naiel, M.A.E. Therapeutic uses and applications of bovine lactoferrin in aquatic animal medicine: An overview. Vet. Res. Commun. 2023, 47, 1015–1029. [Google Scholar] [CrossRef]
- Legros, J.; Jan, S.; Bonnassie, S.; Gautier, M.; Croguennec, T.; Pezennec, S.; Cochet, M.F.; Nau, F.; Andrews, S.C.; Baron, F. The role of ovotransferrin in egg-white antimicrobial activity: A review. Foods 2021, 10, 823. [Google Scholar] [CrossRef]
- Rosa, L.; Cutone, A.; Lepanto, M.S.; Paesano, R.; Valenti, P. Lactoferrin: A natural glycoprotein involved in iron and inflammatory homeostasis. Int. J. Mol. Sci. 2017, 18, 1985. [Google Scholar] [CrossRef]
- Wu, J.; Acero-Lopez, A. Ovotransferrin: Structure, bioactivities, and preparation. Food Res. Int. 2012, 46, 480–487. [Google Scholar] [CrossRef]
- Zarzosa-Moreno, D.; Avalos-Gómez, C.; Ramírez-Texcalco, L.S.; Torres-López, E.; Ramírez-Mondragón, R.; Hernández-Ramírez, J.O.; Serrano-Luna, J.; de la Garza, M. Lactoferrin and its derived peptides: An alternative for combating virulence mechanisms developed by pathogens. Molecules 2020, 25, 5763. [Google Scholar] [CrossRef] [PubMed]
- Rathnapala, E.C.N.; Ahn, D.U.; Abeyrathne, S. Functional properties of ovotransferrin from chicken egg white and its derived peptides: A review. Food Sci. Biotechnol. 2021, 30, 619–630. [Google Scholar] [CrossRef] [PubMed]
- Dierick, M.; Van der Weken, H.; Rybarczyk, J.; Vanrompay, D.; Devriendt, B.; Cox, E. Porcine and Bovine Forms of Lactoferrin Inhibit Growth of Porcine Enterotoxigenic Escherichia coli and Degrade Its Virulence Factors. Appl. Environ. Microbiol. 2020, 86, e00524-20. [Google Scholar] [CrossRef]
- Kieckens, E.; Rybarczyk, J.; Barth, S.A.; Menge, C.; Cox, E.; Vanrompay, D. Effect of lactoferrin on release and bioactivity of Shiga toxins from different Escherichia coli O157:H7 strains. Vet. Microbiol. 2017, 202, 29–37. [Google Scholar] [CrossRef] [PubMed]
- Ochoa, T.J.; Noguera-Obenza, M.; Ebel, F.; Guzman, C.A.; Gomez, H.F.; Cleary, T.G. Lactoferrin impairs type III secretory system function in enteropathogenic Escherichia coli. Infect. Immun. 2003, 71, 5149–5155. [Google Scholar] [CrossRef]
- Beeckman, D.S.; Van Droogenbroeck, C.M.A.D.; De Cock, B.J.A.; Van Oostveldt, P.; Vanrompay, D.C.G. Effect of ovotransferrin and lactoferrins on Chlamydophila psittaci adhesion and invasion in HD11 chicken macrophages. Vet. Res. 2007, 38, 729–739. [Google Scholar] [CrossRef]
- Sessa, R.; Di Pietro, M.; Filardo, S.; Bressan, A.; Rosa, L.; Cutone, A.; Frioni, A.; Berlutti, F.; Paesano, R.; Valenti, P. Effect of bovine lactoferrin on Chlamydia trachomatis infection and inflammation. Biochem. Cell Biol. 2017, 95, 34–40. [Google Scholar] [CrossRef]
- Niaz, B.; Saeed, F.; Ahmed, A.; Imran, M.; Maan, A.A.; Khan, M.K.I.; Tufail, T.; Anjum, F.M.; Hussain, S.; Suleria, H.A.R. Lactoferrin (LF): A natural antimicrobial protein. Int. J. Food Prop. 2019, 22, 1626–1641. [Google Scholar] [CrossRef]
- Baron, F.; Jan, S.; Gonnet, F.; Pasco, M.; Jardin, J.; Giudici, B.; Gautier, M.; Guérin-Dubiard, C.; Nau, F. Ovotransferrin plays a major role in the strong bactericidal effect of egg white against the bacillus cereus group. J. Food Prot. 2014, 77, 955–962. [Google Scholar] [CrossRef]
- Leon-Sicairos, N.; Canizalez-Roman, A.; de la Garza, M.; Reyes-Lopez, M.; Zazueta-Beltran, J.; Nazmi, K.; Gomez-Gil, B.; Bolscher, J.G. Bactericidal effect of lactoferrin and lactoferrin chimera against halophilic Vibrio parahaemolyticus. Biochimie 2009, 91, 133–140. [Google Scholar] [CrossRef] [PubMed]
- Acosta-Smith, E.; Viveros-Jiménez, K.; Canizalez-Román, A.; Reyes-Lopez, M.; Bolscher, J.G.M.; Nazmi, K.; Flores-Villaseñor, H.; Alapizco-Castro, G.; de la Garza, M.; Martínez-Garcia, J.J.; et al. Bovine lactoferrin and lactoferrin-derived peptides inhibit the growth of Vibrio cholerae and other Vibrio species. Front. Microbiol. 2018, 8, 2633. [Google Scholar] [CrossRef] [PubMed]
- Chand, R.K.; Sahoo, P.K.; Kumari, J.; Pillai, B.R.; Mishra, B.K. Dietary administration of bovine lactoferrin influences the immune ability of the giant freshwater prawn Macrobrachium rosenbergii (de Man) and its resistance against Aeromonas hydrophila infection and nitrite stress. Fish Shellfish Immunol. 2006, 21, 119–129. [Google Scholar] [CrossRef] [PubMed]
- Zhuang, Y.; Huang, H.; Liu, X.L.; Wang, N.A.; Zhong, G.F. Effect of bovine lactoferricin on the growth performance, digestive capacity, immune responses and disease resistance in Pacific white shrimp, Penaeus vannamei. Fish Shellfish Immunol. 2022, 123, 282–289. [Google Scholar] [CrossRef] [PubMed]
- Tjørve, K.M.C.; Tjørve, E. The use of Gompertz models in growth analyses, and new Gompertz-model approach: An addition to the Unified-Richards family. PLoS ONE 2017, 12, e0178691. [Google Scholar] [CrossRef]
- Spratt, M.R.; Lane, K. Navigating Environmental Transitions: The Role of Phenotypic Variation in Bacterial Responses. In Proceedings of the mBio, Geneva, Switzerland, 28 November–16 December 2022. [Google Scholar]
- León-Sicairos, N.; Angulo-Zamudio, U.A.; de la Garza, M.; Velázquez-Román, J.; Flores-Villaseñor, H.M.; Canizalez-Román, A. Strategies of Vibrio parahaemolyticus to acquire nutritional iron during host colonization. Front. Microbiol. 2015, 6, 702. [Google Scholar] [CrossRef]
- Yamamoto, S.; Okujo, N.; Matsuura, S.; Fujiwara, I.; Fujita, Y.; Al, E.T. Siderophore-Mediated Utilization of Iron Bound Transferrin by Vibrio parahaemolyticus. Microbiol. Immunol. 1994, 38, 687–693. [Google Scholar] [CrossRef]
- Ekins, A.; Khan, A.G.; Shouldice, S.R.; Schryvers, A.B. Lactoferrin receptors in Gram-negative bacteria: Insights into the iron acquisition process. Biometals 2004, 17, 235–243. [Google Scholar] [CrossRef]
- Osei-Adjei, G.; Huang, X.; Zhang, Y. The extracellular proteases produced by Vibrio parahaemolyticus. World J. Microbiol. Biotechnol. 2018, 34, 68. [Google Scholar] [CrossRef]
- Ashrafudoulla, M.; Na, K.W.; Hossain, M.I.; Mizan, M.F.R.; Nahar, S.; Toushik, S.H.; Roy, P.K.; Park, S.H.; Ha, S.D. Molecular and pathogenic characterization of Vibrio parahaemolyticus isolated from seafood. Mar. Pollut. Bull. 2021, 172, 112927. [Google Scholar] [CrossRef]
- Mizan, M.F.R.; Jahid, I.K.; Kim, M.; Lee, K.H.; Kim, T.J.; Ha, S.D. Variability in biofilm formation correlates with hydrophobicity and quorum sensing among Vibrio parahaemolyticus isolates from food contact surfaces and the distribution of the genes involved in biofilm formation. Biofouling 2016, 32, 497–509. [Google Scholar] [CrossRef]
- Ahmed, H.A.; El Bayomi, R.M.; Hussein, M.A.; Khedr, M.H.E.; Abo Remela, E.M.; El-Ashram, A.M.M. Molecular characterization, antibiotic resistance pattern and biofilm formation of Vibrio parahaemolyticus and V. cholerae isolated from crustaceans and humans. Int. J. Food Microbiol. 2018, 274, 31–37. [Google Scholar] [CrossRef] [PubMed]
- Zhu, W.; Gao, J.; Liu, H.; Liu, J.; Jin, T.; Qin, N.; Ren, X.; Xia, X. Antibiofilm effect of sodium butyrate against Vibrio parahaemolyticus. Food Control 2022, 131, 108422. [Google Scholar] [CrossRef]
- Gu, D.; Meng, H.; Li, Y.; Ge, H.; Jiao, X. A GntR family transcription factor (VPA1701) for swarming motility and colonization of Vibrio parahaemolyticus. Pathogens 2019, 8, 235. [Google Scholar] [CrossRef] [PubMed]
- Gode-Potratz, C.J.; Kustusch, R.J.; Breheny, P.J.; Weiss, D.S.; McCarter, L.L. Surface sensing in Vibrio parahaemolyticus triggers a programme of gene expression that promotes colonization and virulence. Mol. Microbiol. 2011, 79, 240–263. [Google Scholar] [CrossRef]
- Danchik, C.; Casadevall, A. Role of Cell Surface Hydrophobicity in the Pathogenesis of Medically-Significant Fungi. Front. Cell. Infect. Microbiol. 2021, 10, 594973. [Google Scholar] [CrossRef]
- Krasowska, A.; Sigler, K. How microorganisms use hydrophobicity and what does this mean for human needs? Front. Cell. Infect. Microbiol. 2014, 4, 112. [Google Scholar] [CrossRef]
- Packiavathy, I.A.S.V.; Sasikumar, P.; Pandian, S.K.; Veera Ravi, A. Prevention of quorum-sensing-mediated biofilm development and virulence factors production in Vibrio spp. by curcumin. Appl. Microbiol. Biotechnol. 2013, 97, 10177–10187. [Google Scholar] [CrossRef]

| Vp M0904 | |||||
|---|---|---|---|---|---|
| Treatment (mg/mL) | bLF | OT | |||
| YM | Lag | YM | Lag | ||
| 101 CFU/mL | 10 | 0.075 (****) | / | 0.656 (****) | 13.375 (****) |
| 5 | 0.080 (****) | / | 0.598 (****) | 13.500 (****) | |
| 1 | 0.370 (****) | 16.382 (****) | 0.580 (****) | 11.757 (****) | |
| 0.1 | 0.588 (ns) | 10.700 (ns) | 0.601 (****) | 9.125 (ns) | |
| 0.01 | 0.458 (****) | 10.546 (*) | 0.485 (ns) | 9.509 (ns) | |
| 0.001 | 0.541 (****) | 11.084 (ns) | 0.457 (ns) | 9.527 (ns) | |
| 0 | 0.605 | 11.142 | 0.450 | 9.625 | |
| 103 CFU/mL | 10 | / | / | 0.675 (****) | 10.176 (****) |
| 5 | / | / | 0.626 (****) | 10.068 (****) | |
| 1 | 0.493 (****) | 11.972 (****) | 0.598 (****) | 8.160 (**) | |
| 0.1 | 0.653 (*) | 8.644 (ns) | 0.571 (****) | 7.481 (ns) | |
| 0.01 | 0.610 (ns) | 7.907 (ns) | 0.498 (***) | 7.478 (ns) | |
| 0.001 | 0.647 (*) | 8.396 (ns) | 0.474 (ns) | 7.213 (ns) | |
| 0 | 0.613 | 8.475 | 0.451 | 7.098 | |
| Vp TW01 | |||||
| Treatment (mg/mL) | bLF | OT | |||
| YM | Lag | YM | Lag | ||
| 101 CFU/mL | 10 | / | / | 0.801 (*) | 13.694 (****) |
| 5 | / | / | 0.908 (***) | 12.802 (****) | |
| 1 | 0.530 (ns) | 18.256 (****) | 1.008 (****) | 9.078 (ns) | |
| 0.1 | 0.576 (ns) | 8.664 (*) | 1.036 (****) | 7.392 (ns) | |
| 0.01 | 0.572 (ns) | 8.977 (ns) | 0.801 (ns) | 8,450 (ns) | |
| 0.001 | 0.581 (ns) | 9.588 (*) | 0.751 (ns) | 8.248 (ns) | |
| 0 | 0.558 | 9.148 | 0.695 | 8.051 | |
| 103 CFU/mL | 10 | / | / | 0.977 (****) | 9.181 (****) |
| 5 | / | / | 1.027 (****) | 8.723 (***) | |
| 1 | 0.498 (****) | 12.184 (****) | 1.070 (****) | 6.106 (ns) | |
| 0.1 | 0.564 (ns) | 6.439 (ns) | 1.088 (****) | 5.123 (ns) | |
| 0.01 | 0.560 (ns) | 6.532 (ns) | 0.804 (ns) | 5.394 (ns) | |
| 0.001 | 0.574 (ns) | 6.643 (ns) | 0.731 (ns) | 5.711 (ns) | |
| 0 | 0.561 | 6.624 | 0.724 | 5.825 | |
| Vp PV1 | |||||
| Treatment (mg/mL) | bLF | OT | |||
| YM | Lag | YM | Lag | ||
| 101 CFU/mL | 10 | / | / | 0.561 (****) | 16.184 (****) |
| 5 | / | / | 0.661 (****) | 13.651 (****) | |
| 1 | 0.523 (****) | 13.489 (****) | 1.290 (**) | 12.527 (****) | |
| 0.1 | 1.137 (ns) | 8.645 (ns) | 1.559 (ns) | 8.977 (ns) | |
| 0.01 | 1.447 (***) | 7.303 (ns) | 1.564 (ns) | 9.411 (ns) | |
| 0.001 | 1.065 (ns) | 8.107 (ns) | 1.586 (ns) | 9.058 (ns) | |
| 0 | 1.029 | 8.191 | 1.668 | 8.613 | |
| 103 CFU/mL | 10 | / | / | 0.621 (****) | 12.428 (****) |
| 5 | / | / | 0.964 (****) | 11.916 (****) | |
| 1 | 0.528 (***) | 9.032 (***) | 1.429 (ns) | 8.674 (***) | |
| 0.1 | 1.204 (ns) | 5.386 (ns) | 1.544 (ns) | 6.848 (ns) | |
| 0.01 | 1.615 (ns) | 5.110 (ns) | 1.554 (ns) | 6.760 (ns) | |
| 0.001 | 1.534 (ns) | 4.845 (ns) | 1.585 (ns) | 6.687 (ns) | |
| 0 | 1.375 | 4.584 | 1.565 | 6.939 | |
Disclaimer/Publisher’s Note: The statements, opinions and data contained in all publications are solely those of the individual author(s) and contributor(s) and not of MDPI and/or the editor(s). MDPI and/or the editor(s) disclaim responsibility for any injury to people or property resulting from any ideas, methods, instructions or products referred to in the content. |
© 2023 by the authors. Licensee MDPI, Basel, Switzerland. This article is an open access article distributed under the terms and conditions of the Creative Commons Attribution (CC BY) license (https://creativecommons.org/licenses/by/4.0/).
Share and Cite
Vandeputte, M.; Verhaeghe, M.; Willocx, L.; Bossier, P.; Vanrompay, D. Bovine Lactoferrin and Hen Ovotransferrin Affect Virulence Factors of Acute Hepatopancreatic Necrosis Disease (AHPND)-Inducing Vibrio parahaemolyticus Strains. Microorganisms 2023, 11, 2912. https://doi.org/10.3390/microorganisms11122912
Vandeputte M, Verhaeghe M, Willocx L, Bossier P, Vanrompay D. Bovine Lactoferrin and Hen Ovotransferrin Affect Virulence Factors of Acute Hepatopancreatic Necrosis Disease (AHPND)-Inducing Vibrio parahaemolyticus Strains. Microorganisms. 2023; 11(12):2912. https://doi.org/10.3390/microorganisms11122912
Chicago/Turabian StyleVandeputte, Marieke, Margaux Verhaeghe, Lukas Willocx, Peter Bossier, and Daisy Vanrompay. 2023. "Bovine Lactoferrin and Hen Ovotransferrin Affect Virulence Factors of Acute Hepatopancreatic Necrosis Disease (AHPND)-Inducing Vibrio parahaemolyticus Strains" Microorganisms 11, no. 12: 2912. https://doi.org/10.3390/microorganisms11122912
APA StyleVandeputte, M., Verhaeghe, M., Willocx, L., Bossier, P., & Vanrompay, D. (2023). Bovine Lactoferrin and Hen Ovotransferrin Affect Virulence Factors of Acute Hepatopancreatic Necrosis Disease (AHPND)-Inducing Vibrio parahaemolyticus Strains. Microorganisms, 11(12), 2912. https://doi.org/10.3390/microorganisms11122912

